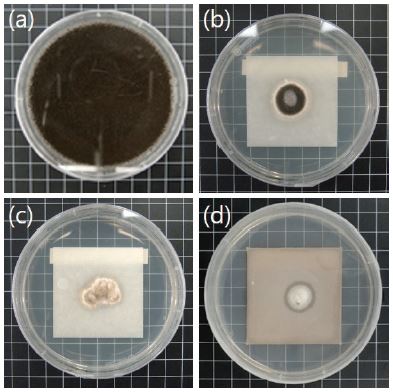
https://cdn.apub.kr/journalsite/sites/ktappi/2017-049-04/N0460490414/images/KTAPPI_2017_v49n4_134_f007.jpg
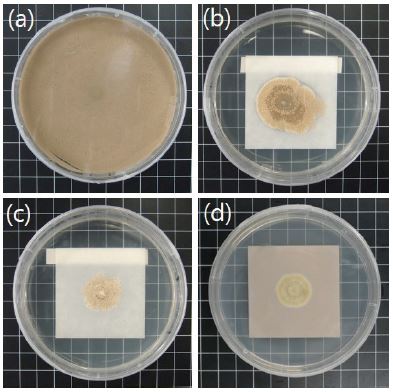
https://cdn.apub.kr/journalsite/sites/ktappi/2017-049-04/N0460490414/images/KTAPPI_2017_v49n4_134_f008.jpg

1. 서 론
서책이나 서화와 같은 지류 문화재는 세월의 흐름 및 장시간의 보관 기간에 따라 물리적·화학적·생물학적의 다양한 요인들에 의해 손상되거나 재질의 노화를 야기하게 된다. 특히 지류문화재의 물리화학적 강도를 저하시키거나 변색과 같은 생물학적 변화를 일으키는 곰팡이는 종이의 수명을 감축시키는 주요 원인이 되고 있다. 곰팡이류와 같은 미생물의 침해를 막기 위해 박물관 및 기록관 등의 수장고에서는 온·습도 조절 및 항균물질 등에 의한 생물학적 요인의 제어를 통해 체계적으로 지류 문화재를 관리하고 있다. 또한, 종이 자체의 항진균성을 높이기 위한 연구도 이루어지고 있다.
다양한 금속계 나노 입자 중 은 나노입자는 박테리아, 곰팡이, 바이러스 등 미생물에 대한 항균 특성을 지니는 것으로 알려져 있다.1) 은 나노입자의 항균기작은 미생물과 은 나노입자의 접촉에 의한 항균기작,2) 용출된 Ag+ 이온으로 인한 기작3) 등 다양한 견해들이 제시되고 있다. 또한, 은 나노 입자의 항균성을 발현에 영향을 미치는 요소는 입자의 크기와 분산에 있으나 은 나노입자의 응집현상은 항균성 발현의 큰 걸림돌이 된다. 따라서 은 나노입자의 분산을 위해 나노 사이즈보다 큰 이산화티탄, 산화아연, 산화마그네슘 등의 표면에 core-shell 형태로 코팅하여 분산성을 높여 사용하기도 한다.4)
산화아연은 미국의 식품의약국(FDA, 2011)에 의해 안전한 물질로 인정되었으며 항균활성에 대해 다양한 연구가 진행되었다. 산화아연의 항균 기작은 산화아연 자체에서 생성하는 reactive oxygen species(ROS)가 야기하는 세포 손상이나 용해된 Zn+2 이온의 항균기작, 산화아연 자체의 항균성으로 설명될 수 있다.5-8) 항균성을 지닌 두 입자의 복합체인 Ag/ZnO 복합체는 항균성이 뛰어나다. 따라서 Ag/ZnO 복합체는 식품 포장업계, 항균 코팅개발 및 병원균 감염을 예방해야 하는 외과용 기기 코팅 분야에서 사용되고 있으며, 이러한 Ag/ZnO 항균성을 종이에 접목하면 항균성을 발현시켜 보존성을 향상시킬 수 있을 것으로 판단된다.
Ag/ZnO 복합체의 합성법으로는 졸-겔법, 공침법, 수열합성법, 펄스레이저 증축법, 광촉매법 및 열분해법 등의 방식을 적용한다.9-11) 그러나 높은 온도 및 압력 조건과 긴 반응 시간이 요구되어 상업용이나 실험실적 연구에 제한적인 방법이다. 따라서 본 연구에서는 UV-C 광원을 이용한 간단하고 신속한 photo deposition method를 이용하여 Ag/ZnO 복합체를 제조하였다. Photo deposi-tion method의 메커니즘은 ZnO 수용액에 전구체인 AgNO3를 첨가하여 Ag+, NO3- 이온을 생성시키고 수용액에 높은 출력의 UV 광을 조사하여 ZnO에서 e-를 방출시켜 Ag+ 와 e-를 결합하여 Ag를 생성하며, ZnO 표면에 Ag를 도핑하는 방법이다.10)
본 연구에서는 제조한 Ag/ZnO의 항균성을 비교하기 위하여 Ag/ZnO, 마이크로사이즈 산화아연, 나노사이즈 산화아연을 보류 시스템 조건에 따라 충전율을 달리 하여 수초지를 제작하였으며, 수초지의 물리적·광학적 특성 및 항진균 특성에 미치는 영향을 평가하였다.
2. 재료 및 방법
2.1 공시재료
본 연구에서는 시트상의 침엽수 및 활엽수 표백크라프트 펄프를 이용하였으며, KS M ISO 5264에 의거하여 여수도 350 mL CSF로 고해하여 사용하였다. 고해한 펄프는 침엽수:활엽수 비율을 3:7로 지료를 혼합하여 사용하였다.
보류시스템에 사용된 약품은 S사에서 제공받은 cationic starch(DS: 0.06), AKD(alkyl ketene dimer), cationic polyacrylamide(molecular weight: 8.0×106 g/mol, charge density: 0.8 µeq/g), bentonite 등을 사용하였다. 충전제의 보류에 따른 물리적·광학적 특성 및 항진균성을 평가하기 위하여 입자 크기 1.1-1.2 µm, 비표면적 4.3-4.5 m2/g의 마이크로 사이즈 산화아연(m-ZnO), 입자크기 30 nm, 비표면적 40 m2/g의 나노 사이즈 산화아연(n-ZnO) 및 합성한 Ag/ZnO 복합체를 사용하였다.
Ag/ZnO 복합체 제조를 위해 산화아연(m-ZnO), AgNO3(DAEJUNG, Korea), methanol(DAEJUNG, Korea)을 사용하였다. 사용된 UV-C 광원은 253.7 nm 파장대역을 조사하는 Sankyo Denk 사의 2중관 램프를 사용하였다.
Ag/ZnO의 항진균성 분석을 위해 Aspergillus niger (ASN), Trichoderma viride(TRV)를 이용하였다. ASN 및 TRV는 모두 국내의 서고 및 기록물 등에서 분리 동정된 기록이 있으며, ASN의 경우 KS K ISO 13629, KS J 3201, ASTM G-21, ASTM D 2020 등 항곰팡이 관련 실험에 자주 이용되고 있다. TRV의 경우 종이의 강도를 저하시킨다는 결과도 보고된 바 있다.12)
2.2 Ag/ZnO 제조
Ag/ZnO 복합체 제조는 photo deposition method를 이용하여 합성하였다. 2.0 g의 마이크로 사이즈 ZnO 분말을 200 mL의 증류수에 첨가한 다음 0.2 mol의 AgNO3의 수용액과 에탄올 2 mL를 부가한 후 현탁액을 자성 교반하며 UV 램프로 2시간 동안 조사하였다. 조사 후 혼합용액을 여과하고, 증류수로 완전히 세척 후 100°C에서 2시간 동안 건조시켰다.
2.3 XRD 및 SEM-EDS 분석
복합체 제조 전 XRD 및 SEM-EDS를 이용하여 ZnO와 제조한 Ag/ZnO의 성분 분석을 실시하였다. XRD (RIGAKU, D/MAX-2500V)의 측정 조건은 40 kV/30 mA, 주사범위 2θ=30-80°, scan speed는 2°/min이었다. SEM-EDS(JEOL, JSM-7610F)는 시료의 Pt 코팅 후 전압 5.0 kv, 배율 1,000배 및 10,000배로 촬영하였다.
2.4 수초지 제조
ZnO 및 Ag/ZnO의 보류 조건에 따른 종이의 물리적·광학적 특성 및 항진균성을 검토하기 위해 보류율 5- 15%의 수초지를 제작하였다. m-ZnO, n-ZnO 및 Ag/ZnO 복합체를 지층에 충전시키기 위해 마이크로파티클 보류 시스템을 적용하여 전건섬유 대비 충전제의 충전율을 5%, 10%, 15%로 조절하였다. KS M ISO 5296에 의거하여 RDA(retention and drainage analyzer)를 사용하여 평량 80 g/m2의 수초지를 제조하였다. 수초지는 온도 23±1°C, 상대습도 50±2% 항온·항습 조건에서 24시간 이상 조습처리를 실시 후 표준 시험법에 의거하여 평량, 두께, 회분(KS M ISO 1762), 인장강도(KS M ISO 1924-2), C 광원을 이용한 ISO 백색도(KS M ISO 2470-1), 불투명도(KS M ISO 1762)를 측정하였다.
2.5 Ag/ZnO 처리에 따른 항진균성 평가
선정된 2종의 진균을 종이에 접종하기 위해 계대배양을 하였다. Potato dextrose agar(PDA)를 이용하여 원균을 25°C에서 3일간 배양한 후, PDA 배지에서 계대 배양된 균체 10 floc을 potato dextrose broth(PDB) 400 mL에 첨가하고 밀봉하여 5일간 25°C 150 rpm 조건의 shaking incubator에서 전배양을 실시하였다.
수초지에 첨가된 ZnO의 항진균성을 확인하기 위해 ZnO의 크기와 첨가 비율에 따른 균의 생장률을 측정하였다. 각 시료는 3 배수로 준비하였으며 생장률 측정을 위해 수초한 시료를 5×5 cm2로 재단한 후 멸균을 실시하였다. 멸균된 시료는 clean bench에서 지름 90 mm의 페트리디쉬 PDA 배지 위에 올리고 PDB에서 계대 배양한 균을 5 µL씩 시료의 중앙에 접종하고 밀봉하였다. 접종된 시료는 온도 27±1°C, 상대습도 70±5% 조건의 incubator에서 15일간 배양하였으며 5일, 10일, 15일 마다 균의 생장 상태를 이미지 촬영하였으며, 생장된 균의 직경을 계산하여 생장률을 측정하였다. 측정한 생장률은 Eq. 1을 이용하여 생장억제 비율(%inhibition)을 계산하였다.13)Eq. 1에서 Dc는 산화아연을 첨가하지 않은 수초지에서 성장한 곰팡이의 평균 직경(mm), Dt는 Ag/ZnO 및 산화아연을 투입한 수초지에서 성장한 곰팡이의 평균 직경(mm)을 의미한다.
3. 결과 및 고찰
3.1 XRD에 의한 ZnO 및 Ag/ZnO 복합체 파우더의 분석
ZnO 및 Ag/ZnO 복합체 파우더의 구조를 분석하기 위한 XRD 패턴을 Fig. 1에 나타냈으며, 울츠자이트 형태의 일반적인 ZnO를 확인할 수 있었다. Fig. 1의 a 및 b 패턴에서 ZnO의 주요 회절 peak(100), (002), (101), (102), (110), (103), (200), (112), (201)과 일치하는 것을 확인 할 수 있었다.11,14)Fig. 1의 b에서는 a와 다른 2개의 peak가 확인되었으며, 이는 (111) 및 (200) peak로서 face-center-cubic(fcc) 구조의 silver를 나타낸다.11)
3.2 SEM-EDS에 의한 ZnO 및 Ag/ZnO 복합체 파우더의 분석
Fig. 2 및 Table 1은 ZnO 및 Ag/ZnO 파우더의 전자현미경(SEM) 이미지 이다. 입자의 구성성분을 정확하게 확인하기 위해 전자현미경에 부착된 EDS를 통해 원소 성분을 확인하였으며, 그 결과 무처리 ZnO에서 Ag는 검출되지 않았지만 Ag/ZnO 도핑한 시료에서는 Ag 성분이 관찰되었다. Fig. 2의 SEM 이미지에서는 ZnO와 Ag/ZnO 입자의 형태적 특성 변화를 관찰할 수 없었다. 그러나 Table 1의 SEM-EDS 결과를 분석해 보면 ZnO 입자에서는 Ag 성분이 검출되지 않았지만 Ag/ZnO 복합체의 경우 Zn 36.69%, O 35.66%, Ag 0.47%의 원자 비율로 분포하는 것을 확인할 수 있었다.

Fig. 2.
Scanning electron microphotographs and X-ray energy dispersion spectra of ZnO and Ag/ZnO composite.
Table 1.
Compositions of elements for ZnO and Ag/ZnO composite by scanning electron microphotographs
| Filler | Element | Wt% | Wt% Sigma | Atomic % |
|---|---|---|---|---|
| ZnO | C | 23.71 | 0.35 | 50.66 |
| O | 16.00 | 0.20 | 25.66 | |
| Zn | 60.30 | 0.32 | 23.68 | |
| Ag | - | - | - | |
| Ag/ZnO composite | C | 9.91 | 0.33 | 27.18 |
| O | 17.82 | 0.20 | 36.69 | |
| Zn | 70.75 | 0.34 | 35.66 | |
| Ag | 1.52 | 0.20 | 0.47 |
Table 2.
Development of fungi Aspergillus niger on sheet according to the addition of m-ZnO, n-ZnO, and Ag/ZnO composite
3.3 ZnO 및 Ag/ZnO 복합체 파우더를 적용한 시트의 물리·광학적 특성
Fig. 3은 m-ZnO, n-ZnO 및 Ag/ZnO 복합체를 충전제로서 5%, 10%, 15% 함량으로 조절하여 초지한 시트의 인장강도 결과이다. n-ZnO의 경우 나노 입자들이 응집하여 섬유 네트웍의 표면에 보류됨으로써 m-ZnO 및 Ag/ZnO 복합체에 의한 보류 조건보다 우수한 인장강도 특성을 나타낸 것으로 사료된다. 입도 크기가 유사한 m-ZnO 및 Ag/ZnO 복합체의 경우 충전율을 증가함에 따라 인장강도는 감소하였으며 Ag/ZnO 복합체 충전은 인장강도 감소폭이 가장 높음을 확인하였다. 이러한 결과로서 ZnO의 경우 섬유와 수소결합을 하지만 Ag/ZnO 복합체의 경우 ZnO 표면을 도포한 Ag 입자들이 섬유 사이에서 수소 결합을 방해한다는 선행 연구 사례가 제시된 적이 있다.15)

Fig. 3.
Changes in tensile index of sheet according to the addition of m-ZnO, n-ZnO, and Ag/ZnO composite.
Fig. 4는 m-ZnO, n-ZnO 및 Ag/ZnO 복합체의 첨가량 변화에 따라 초지한 시트의 내절도 결과이다. n-ZnO를 첨가한 시트의 내절도는 m-ZnO 및 Ag/ZnO 복합체를 충전한 시트에 비해 높게 나타났으며, 이는 인장강도의 결과와 마찬가지로 n-ZnO의 경우 보류 시 응집체를 형성함에 따라 섬유간 결합을 방해하지 않고 치밀한 시트 구조를 형성할 수 있었기 때문으로 사료된다. 동일한 지료 조건에서 m-ZnO 및 Ag/ZnO 복합체를 충전한 경우 내절도는 상대적으로 낮게 나타났다.

Fig. 4.
Changes in folding endurance of sheet according to the addition of m-ZnO, n-ZnO, and Ag/ZnO composite.
m-ZnO, n-ZnO 및 Ag/ZnO 복합체의 함량을 5%, 10% 및 15%로 조절하여 초지한 시트의 백색도 및 불투명도 결과를 Figs. 5와 6에 나타냈다. n-ZnO 및 m-ZnO를 첨가한 시트의 경우 충전율이 높아질수록 백색도는 각각 76.8%, 83.8%, 81.7% ISO로 개선되는 결과를 나타냈으며, 이는 입도와 상관없이 ZnO의 우수한 광학적 특성 때문으로 사료된다. m-ZnO에 비해 n-ZnO의 백색도가 다소 낮은 것은 입자의 응집으로 인한 빛의 산란 특성과 관련이 있을 것으로 판단된다. Ag/ZnO 복합체의 경우 ZnO와 상반되는 결과를 나타냈으며, 첨가량을 증가할수록 백색도는 감소하는 경향을 나타냈다. 이러한 결과는 ZnO 입자에 Ag 입자가 표면 증착이 일어나 백색도는 저하되었으며 첨가량을 증가시킬수록 시트의 백색도가 낮아지는 원인으로 판단된다.

Fig. 5.
Changes in brightness of sheet according to the addition of m-ZnO, n-ZnO, and Ag/ZnO composite.
시트의 불투명도도 m-ZnO, n-ZnO, Ag/ZnO 복합체의 첨가율을 증가함에 따라 각각 무첨가 조건의 83.7%에서 91.0%, 87.3% 및 99.2%까지 향상 되었다. Ag/ZnO 복합체의 경우 백색도와 상반되는 결과를 나타냈으며 Ag/ZnO 복합체에 의한 빛의 흡수에 의해 나타난 결과로 판단된다.
3.4 ZnO 및 Ag/ZnO 복합체 파우더를 적용한 시트의 항진균성 평가
m-ZnO, n-ZnO 및 Ag/ZnO 복합체 충전에 따른 시트의 항진균성 발현을 확인하기 위해 진균을 접종 후 15일간 균의 성장을 확인하였다. Tables 2와 3은 ASN 및 TRV 2종에 대한 균의 포자 지름과 균의 상태를 나타낸 결과이며, Figs. 7과 8은 15일간 균의 성장을 나타낸 이미지이다. 충전제를 첨가하지 않은 수초지의 경우 5일 경과 후 ASN 균이 성장하여 포자 반경의 크기가 시트 시료를 초과하는 결과를 나타냈다. m-ZnO를 첨가한 시트의 경우 5%를 첨가한 수초지에서 15일 경과 후 균사 반경이 시트 시료의 크기를 초과하는 것을 확인할 수 있었으며, 10% 및 15% 첨가한 시트의 경우 첨가량을 증가할수록 균의 성장이 더디어지는 것을 확인하였다. n-ZnO를 첨가한 시트에서는 15일 동안 시편의 크기를 초과할 정도로 성장하지 못했으며 m-ZnO와 동일하게 첨가율을 증가했을 경우 균사의 성장은 보다 늦어짐을 확인하였다. 또한, m-ZnO를 첨가한 시트에 비해 n-ZnO를 첨가한 시트의 경우에는 균의 성장이 크게 억제되는 것을 확인할 수 있었다. Ag/ZnO 복합체의 경우 5일 경과 후부터 5-15% 조건까지 첨가한 모든 종류의 시트에서는 균의 포자가 전혀 생성되지 못하고 흰색 균사만 퍼지는 것을 확인할 수 있었다. 또한, 접종 시간의 경과에 따라 균의 성장은 ZnO를 첨가한 시트에 비해 늦어짐을 확인할 수 있었으며, 이러한 결과는 ASN 균에 대해 Ag/ZnO 복합체의 항진균성이 가장 우수한 것으로 나타났다.
Table 3.
Development of the fungi Trichoderma viride on paper added m-ZnO, n-ZnO, and Ag/ZnO composite
Fig. 7.
Optical image of fungi development by Aspergillus niger (Incubation condition: 27±1°C, 15 days, 15% addition amount of m-ZnO, n-ZnO and Ag/ZnO): (a) Controlled sheet, (b) m-ZnO loaded sheet, (c) n-ZnO loaded sheet, and (d) Ag/ZnO loaded sheet.
Fig. 8.
Optical image of fungi development by Trichoderma viride (Incubation condition: 27±1°C, 15 days, 15% addition amount of m-ZnO, n-ZnO and Ag/ZnO): (a) Controlled sheet, (b) m-ZnO loaded sheet, (c) n-ZnO loaded sheet, and (d) Ag/ZnO loaded sheet.
TRV 균의 성장은 ASN에 비해 빠르게 나타났으며, ASN과 동일하게 충전제의 첨가에 따라 성장이 억제되는 것을 확인할 수 있었다. 접종 5일 후 충전제를 첨가하지 않은 시트의 경우 균의 포자 직경이 시험 시편의 넓이 만큼 성장한 것을 확인할 수 있었다. Ag/ZnO 복합체를 첨가한 시트의 경우 균의 초기 성장은 빨랐으나 일정한 시간 경과 후에는 균사의 확장이 늦어짐을 확인할 수 있었다.
Table 4는 Eq. 1에 따라 균 접종 15일 후 m-ZnO, n-ZnO 및 Ag/ZnO 복합체 첨가에 따른 항진균성을 계산한 결과이며, Figs. 5와 6은 m-ZnO, n-ZnO, Ag/ZnO 복합체를 15% 첨가한 시트에 대한 15일 동안의 Aspergillus niger과 Trichoderma viride의 성장을 나타낸 이미지이다.
Table 4.
Percentage of fungal growth inhibition, after 15 days of incubation (calculated from different dosages of m-ZnO, n-ZnO, and Ag/ZnO composite)
| ZnO addition, % | m-ZnO loaded sheet | n-ZnO loaded sheet | Ag/ZnO loaded sheet | |||
|---|---|---|---|---|---|---|
| ASN | TRV | ASN | TRV | ASN | TRV | |
| 5 | 44.4 | 44.4 | 61.5 | 60.1 | 67.3 | 70.5 |
| 10 | 69.9 | 59.4 | 73.0 | 63.5 | 77.6 | 73.8 |
| 15 | 77.0 | 60.6 | 78.4 | 76.6 | 85.7 | 77.1 |
m-ZnO, n-ZnO, Ag/ZnO 복합체의 첨가량을 증가할수록 균 성장 억제율은 향상되는 것을 확인 할 수 있었다. 또한, ZnO의 입도가 작을수록 억제율은 높았으며, Ag/ZnO 복합체가 ZnO에 비해 항진균성이 우수한 것으로 나타났다.
4. 결 론
본 연구에서는 종이의 보존 안정성을 향상시키기 위해 안정적이며 항진균성을 지닌 micro 및 nano 사이즈의 ZnO 입자와 Ag/ZnO 복합체를 충전제로 사용하여 5-15%까지 첨가한 시트의 물리적·광학적 특성 및 항진균성을 평가하였다.
Photo deposition method를 이용하여 Ag/ZnO 복합체를 제조하였고, XRD를 이용하여 ZnO에 Ag가 도핑 처리된 것을 확인하였으며 복합체 제조에서도 간단하며 품질이 우수한 방식임을 확인하였다.
m-ZnO 및 n-ZnO를 첨가한 시트의 경우 Ag/ZnO 복합체를 첨가한 시트에 비해 충전율에 따른 인장강도 및 내절도 감소폭이 낮았고, 특히 n-ZnO를 첨가한 시트의 물리적 강도저하가 가장 낮았다. 백색도는 ZnO 첨가에 따라 향상되었으나 Ag/ZnO 복합체를 첨가한 시트에서는 백색도 감소가 나타났다. 불투명도 특성은 Ag/ZnO 복합체를 적용함에 따라 가장 높게 나타났다. m-ZnO, n-ZnO, Ag/ZnO 복합체의 순으로 충전율을 증가할수록 항진균성은 향상되고, 15일 동안 배양한 ASN과 TRV에 대해 균 성장 억제율은 약 85% 및 78%까지 향상되었다. 따라서 ZnO 및 Ag/ZnO 복합체의 충전량을 조절할 경우 적절한 보존성 및 항균성을 갖는 시트 제조에 적용할 수 있을 것으로 판단된다.




